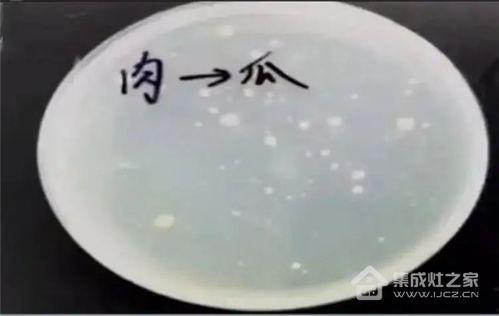

你知道吗?最近网上有个话题炒得火热,那就是“太郎吃瓜”。是不是听起来有点意思?别急,让我来给你详细说说这个话题背后的故事。
太郎是谁?

首先,得先弄清楚这个“太郎”是个啥。原来,太郎是一位在网络上颇有名气的小哥哥,他因为独特的吃瓜方式而走红。据说,这位太郎每次吃瓜都像是在进行一场仪式,那种专注和享受的样子,简直让人忍不住想跟着一起吃瓜。
吃瓜界的“艺术家”
说到太郎的吃瓜技巧,那可真是让人叹为观止。他不仅吃瓜姿势独特,还经常在吃瓜过程中发表一些独到见解。比如,有一次他在吃瓜时,竟然对某个明星的绯闻发表了长达数百字的评论,那认真劲,简直让人以为他是专业的娱记。
吃瓜背后的故事

那么,太郎为什么会这么喜欢吃瓜呢?据他自己说,吃瓜是一种放松的方式,可以让他暂时忘记生活中的烦恼。而且,他还表示,通过吃瓜,他可以了解到很多娱乐圈的幕后故事,这让他觉得生活充满了乐趣。
吃瓜界的“风向标”
有趣的是,太郎的吃瓜态度似乎也影响了一大批网友。很多人开始模仿他的吃瓜姿势,甚至还有一些人专门关注他的吃瓜动态,希望能从中获取一些有用的信息。可以说,太郎已经成为了吃瓜界的“风向标”。
吃瓜背后的社会现象
当然,吃瓜不仅仅是一种娱乐方式,它背后还反映出了当前社会的一些现象。比如,人们对娱乐圈的关注度越来越高,对明星私生活的关注度也越来越大。这种现象在一定程度上,也反映了人们对于娱乐八卦的渴望。
吃瓜的利与弊
虽然吃瓜可以带来一时的快乐,但过度追求八卦也会带来一些负面影响。比如,过度关注明星私生活可能会让人忽视自己的现实生活,甚至影响到心理健康。因此,在享受吃瓜的同时,也要注意适度。
太郎吃瓜这个话题,不仅让人感受到了网络世界的趣味性,还引发了对社会现象的思考。在这个信息爆炸的时代,吃瓜已经成为了一种流行的生活方式。不过,在追求快乐的同时,我们也要保持理性,不要让吃瓜成为生活的全部。怎么样,是不是觉得这个话题很有意思呢?不妨也来试试吃瓜吧,说不定你也能成为下一个“吃瓜达人”哦!


